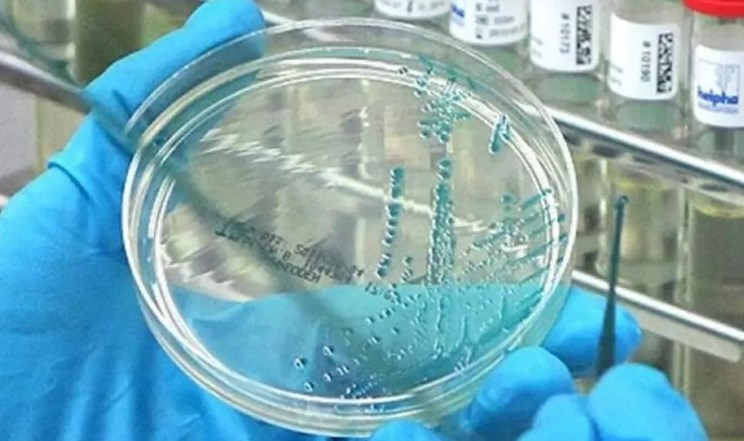
Pandemi2

Enstitünün medikal direktörü Marie-Anne Rameix-Welti, özellikle Avrupa’da artış gösteren kuş gribi vakalarının insanlara bulaşması halinde Covid-19’dan çok daha büyük bir sağlık felaketinin yaşanabileceğini belirtti. Bilim insanlarının en büyük kaygısı ise H5 virüsüne karşı insanlarda doğal bir bağışıklığın bulunmaması.
Covid-19’un etkileri hala sürerken, özellikle Avrupa’da artan kuş gribi vakalarının ciddi bir risk oluşturduğunu söyledi.
H5 VİRÜSÜNÜN İNSANLARA BULAŞMA RİSKİ ARTIYOR
Son dönemde birçok ülkede kuş gribi salgınları yükselişe geçti. Rameix-Welti, bilim dünyasının en büyük endişesinin H5 kuş gribi virüsünün insana ve ardından insandan insana bulaşması olduğunu vurguladı. Böyle bir senaryonun Covid-19’dan çok daha ağır bir tablo yaratabileceği belirtildi.
DOĞAL ANTİKOR YOK, RİSK BU YÜZDEN BÜYÜK
Uzman, insanların H5 virüsüne karşı doğal bir antikora sahip olmadığını söyleyerek bunun en kritik nokta olduğunu ifade etti. Covid-19’un başlangıcında da benzer bir savunmasızlık yaşandığı hatırlatıldı.

ÖLÜM ORANI YÜZDE 48: "HER YAŞ GRUBUNU ETKİLİYOR"
2003 yılından bu yana yaklaşık 1000 H5 vakası tespit edildi. Dünya Sağlık Örgütü verilerine göre ölüm oranı yüzde 48 seviyesinde. Rameix-Welti, Covid-19’un yaşlı ve kronik hastalarda daha ölümcül olduğunu, ancak kuş gribinin her yaştan insanda ağır sonuçlara yol açabileceğini belirtti.
Welti, "Kuş gribi salgını muhtemelen yaşadığımız pandemiden çok daha ağır geçecektir"
ABD'DE H5 VİRÜSÜ BİR CAN ALDI
Kısa süre önce ABD’nin Washington eyaletinde kuş gribi teşhisi konulan bir kişinin hayatını kaybettiği açıklanarak küresel kaygılar arttı.

"AŞI ADAYLARI HAZIR"
Rameix-Welti, Covid-19 sürecinden sonra sağlık sektörünün olası bir salgına daha hazırlıklı olduğunu söyledi. “Şu an aşı adaylarımız hazır ve aşıyı hızlıca nasıl üreteceğimizi biliyoruz” dedi.













